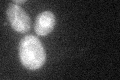
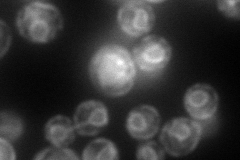
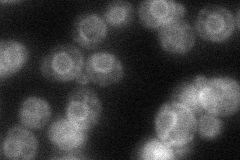
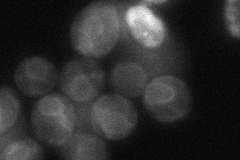
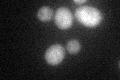
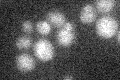

View description
Diacylglycerol kinase, localized to the endoplasmic reticulum (ER); overproduction induces enlargement of ER-like membrane structures and suppresses a temperature-sensitive sly1 mutation; contains a CTP transferase domain
Localization:
Intensity:
Fold change:
Significance:
-
C’ GFP library in SD
ER25.18 -
N' NOP1pr-GFP in SD

ER112.845 -
N' TEF2pr-mCherry in SD
ER140.592 -
N' NATIVEpr-GFP in SD
ER35.7874 -
N' TEF2pr-VC and Cyto-VN in SD
ER45.7291 -
C’ GFP library in SD+DTT
ER19.530.77Yes -
C’ GFP library in SD+H2O2

ER23.240.92No -
C’ GFP library in Starvation Media
ER18.550.73Yes -
C’ GFP library on the background of Pup2-DaMP

ER -
C’ GFP library on the background of CCT mutant

ER19.15630.760401No
